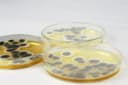
Thumbnail 9

Beschrijving
- Great for a classroom microbiology lesson. Swab different surfaces and watch what grows!
- Each kit includes 20 pre-poured, 15x100mm agar plates, 20 cotton swabs, 10 Pair of Nitrile Gloves, simple step-by-step instructions, and a free science experiment project guide. Contains enough materials for a group of 10 students to perform a true bacteria science experiment with enough agar plates for a control and variable. Have more than 10 students, order 2 or 3 Classroom Kits.
- Our plates are pre-poured. Don't waste time pouring agar. Get right to growing bacteria. The plates are pre-poured, TS (Tryptic Soy) agar. The same nutrient agar used by microbiologists to grow bacteria in the lab. You don’t have to pour your own plates which can be time-consuming and sometimes dangerous for kids.
- Great for encouraging (stem) science, technology, engineering, mathematics for young students. Ideal for elementary, middle school and high school students. Recommended for age 8 and up with adult supervision.
- Free science experiment project guide. Contains easy to follow instructions, experiments and ideas to get the most out of your science kit. When you purchase our kit, you can call or email our knowledgeable staff with any questions. Please visit our website and follow us on facebook and twitter. Diamante scientific offers other great science kits for kids like building a miniature terrarium and growing crystals.
Great for a classroom microbiology lesson. Kit contains enough supplies for ten students and is packaged in individual kits so each student has what he or she needs to perform the experiment. Swab different surfaces and watch what grows! ONE OF THE BEST SELLING BACTERIA GROWING SCIENCE FAIR KITS. Kit Contains: 20 Pre-Poured 15x100mm agar plates20 Cotton Swabs10 Pair Nitrile GlovesStep-by-step instructions ★ FREE eBook filled with experiments to try! When you receive our kit, don't forget to request your free Experiment Project Guide eBook!★ EXPLORE & LEARN! With our pre-poured agar plate bacteria growing set, you don’t have to pour your own plates, which is time consuming and could be dangerous. Learn about microbiology and great for science fair projects. Each plate is coated with a thick nutrient rich agar, which is the same thing microbiologists use in the lab to grow and study bacteria, molds, and other fungi.